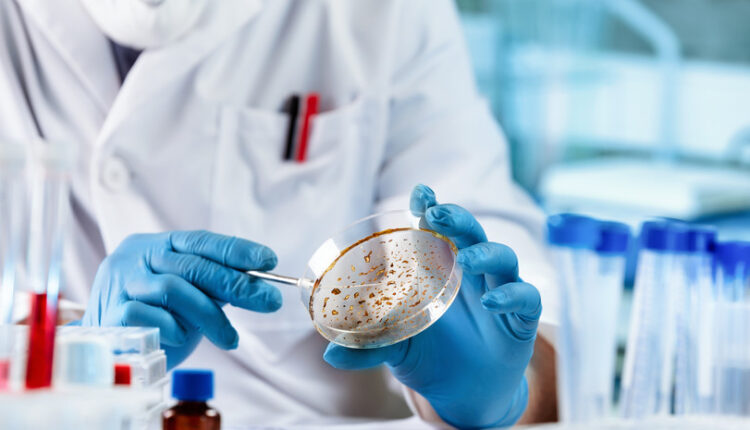

В ВОЗ заявили о резком росте устойчивых к антибиотикам инфекций
Всемирная организация здравоохранения (ВОЗ) опубликовала пресс-релиз, в котором говорится о резком росте устойчивых к антибиотикам бактериальных инфекций.
«В 2023 году каждый шестой лабораторно подтверждённый случай заражения распространёнными бактериальными инфекциями в мире характеризовался устойчивостью к лечению антибиотиками», — говорится в пресс-релизе ВОЗ.
В докладе отмечается, что с 2018 по 2023 год более 40% отслеживаемых комбинаций «патоген-антибиотик» продемонстрировали рост устойчивости.
Уточняется, что эти данные получены на основе информации, представленной в Глобальную систему ВОЗ по контролю за устойчивостью к противомикробным препаратам из более чем 100 стран.
«Устойчивость к противомикробным препаратам опережает достижения современной медицины, угрожая здоровью семей во всём мире», — заявил глава Всемирной организации здравоохранения Тедрос Адханом Гебрейесус.
Самые плохие показатели зарегистрированы в странах Юго-Восточной Азии и Восточного Средиземноморья — там уже треть случаев заражения оказалась резистентна к антибиотикам. При этом в Африке лишь одна пятая случаев заболевания не поддавалась такому лечению.
Подчёркивается, что в настоящий момент наибольшую угрозу представляют грамотрицательные бактериальные патогены.

Комментарии закрыты.